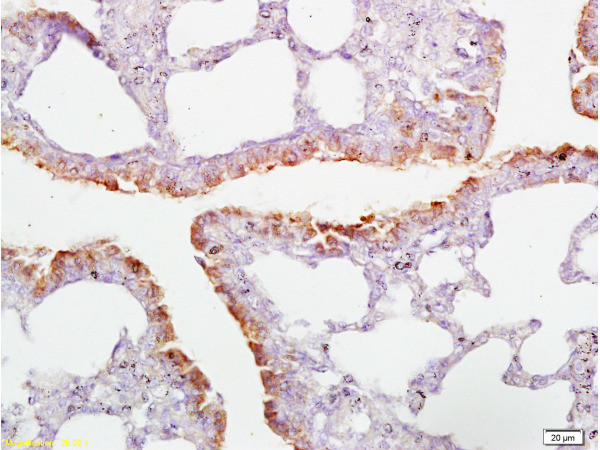
CD2AP Antibody in Immunohistochemistry (Paraffin) (IHC (P))

Search
Bioss
CD2AP Polyclonal Antibody
{{$productOrderCtrl.translations['antibody.pdp.commerceCard.promotion.promotions']}}
{{$productOrderCtrl.translations['antibody.pdp.commerceCard.promotion.viewpromo']}}
{{$productOrderCtrl.translations['antibody.pdp.commerceCard.promotion.promocode']}}: {{promo.promoCode}} {{promo.promoTitle}} {{promo.promoDescription}}. {{$productOrderCtrl.translations['antibody.pdp.commerceCard.promotion.learnmore']}}
产品信息
BS-0512R
种属反应
宿主/亚型
分类
类型
抗原
偶联物
形式
浓度
规格
纯化类型
保存液
内含物
保存条件
运输条件
靶标信息
This gene encodes a scaffolding molecule that regulates the actin cytoskeleton. The protein directly interacts with filamentous actin and a variety of cell membrane proteins through multiple actin binding sites, SH3 domains, and a proline-rich region containing binding sites for SH3 domains. The cytoplasmic protein localizes to membrane ruffles, lipid rafts, and the leading edges of cells. It is implicated in dynamic actin remodeling and membrane trafficking that occurs during receptor endocytosis and cytokinesis. Haploinsufficiency of this gene is implicated in susceptibility to glomerular disease.
仅用于科研。不用于诊断过程。未经明确授权不得转售。
篇参考文献 (0)
生物信息学
蛋白别名: Adapter protein CMS; Cas ligand with multiple SH3 domains; Cas ligand with multiple Src homology (SH) 3 domains; Cas ligand with multiple Src homology 3 (SH3) domains; CD2-associated protein; mesenchyme to epithelium transition protein, SH3 domains; Mesenchyme-to-epithelium transition protein with SH3 domains 1; METS-1; SH3 domain-containing adapter protein; SH3 domain-containing adaptor protein METS-1
基因别名: AL024079; C78928; CD2AP; CMS; METS-1; Mets1
UniProt ID: (Human) Q9Y5K6, (Mouse) Q9JLQ0, (Rat) F1LRS8
Entrez Gene ID: (Human) 23607, (Mouse) 12488, (Rat) 316258